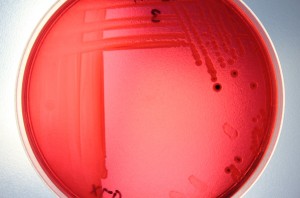
Microbiology Services Analyses Water Cooling Towers Legionella

UKAS ISO/IEC 17025:2017 accreditation
Here at SMS, we’re committed to continual improvement, which is why we’re proud to announce we have achieved accreditation to the latest international standard for testing and calibration laboratories – ISO17025:2017. This new standard verifies the technical competence, facilities, management…
Read More